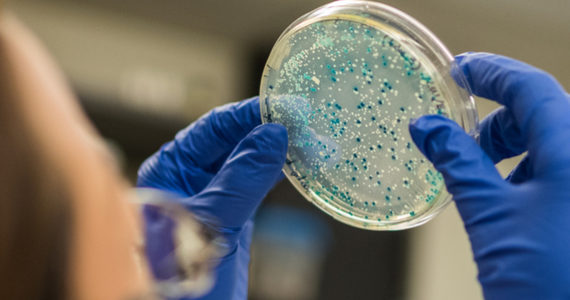
salmonella-kentucky-resistent-antibiotica

Urine verzamelen om groenere stikstofhoudende meststoffen te produceren? Dit idee wint steeds meer terrein, maar er blijven vragen rijzen. Kan urine de resistentie tegen antibiotica in het DNA van de bacteriën die ze bevat, overdragen? Het risico lijkt beperkt.
Boeren verzamelen al millennia lang de urine van hun dieren om de bodem vruchtbaar te maken. Naarmate de circulaire economie steeds meer ingang vindt, lijkt menselijke urine wel een echte goudmijn en veel te kostbaar voor de riool. Ze zou verzameld kunnen worden om zo een tweede leven te krijgen. Er zijn reeds onderzoeksprojecten waarbij menselijke urine opgevangen wordt door middel van speciaal ontworpen urinoirs. Dit helpt bovendien om het waterverbruik te beperken.
Urine bevat stoffen die we kunnen recupereren en verwerken tot producten zoals meststoffen, maar er is een belangrijk obstakel. Urine kan DNA bevatten van bacteriën die resistent zijn geworden tegen antibiotica. Dit DNA in de meststof zou de resistentie kunnen overgedragen op andere organismen.
Meer leesvoer: Duurzamer eten is goed voor de lijn!
Kan urine resistentie tegen antibiotica overdragen?
Twee vorige studies toonden aan dat urine DNA bevat dat resistent is tegen antibiotica. Het is echter niet duidelijk of dit DNA zich kan nestelen in de bodemmicroben en de resistentie tegen antibiotica op hen kan overbrengen. Een onderzoeksteam van de universiteit van Michigan in de Verenigde Staten voerde experimenten uit om dit te achterhalen. Ze gebruikten ‘oude’ urine die enkele maanden was bewaard in een verzegeld vat. We weten dat deze traditionele praktijk de concentratie van ammoniak en de pH-waarde verhoogt en de bacteriële samenstelling van de vloeistof wijzigt.
De onderzoekers incubeerden deze urine met DNA dat genen bevatte die resistent waren tegen tetracycline en ampicilline. Ze stelden vast dat het genetisch materiaal al gauw 99% van zijn capaciteit verloor om resistentie over te dragen aan een bodembacterie.
Meer leesvoer: Probiotica kunnen antibioticagebruik afremmen
Een alternatief voor stikstofhoudende meststoffen
De onderzoekers besluiten uit hun onderzoek dat het risico dat meststoffen uit urine de resistentie tegen antibiotica kunnen verspreiden, laag is. Hoewel ‘laag’ nog niet betekent dat de kans onbestaande is, lijkt deze vaststelling alvast geruststellend. Het zou de ontwikkeling van deze nieuwe methode kunnen aanmoedigen en zo het gebruik van stikstofhoudende meststoffen doen afnemen[ISO T&P1] . De wetenschappers becijferden dat indien de urine van 10 % van de Amerikaanse bevolking op deze manier zou worden gerecycleerd en in meststof zou worden omgezet, het mogelijk zou zijn om:
- miljoenen liters water te besparen;
- dagelijks 300 ton stikstof en 18 ton fosfor te recupereren.